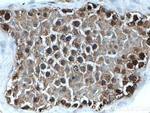
TXNRD1 Antibody in Immunohistochemistry (Paraffin) (IHC (P))

Search
Proteintech
TXNRD1 Polyclonal Antibody
{{$productOrderCtrl.translations['antibody.pdp.commerceCard.promotion.promotions']}}
{{$productOrderCtrl.translations['antibody.pdp.commerceCard.promotion.viewpromo']}}
{{$productOrderCtrl.translations['antibody.pdp.commerceCard.promotion.promocode']}}: {{promo.promoCode}} {{promo.promoTitle}} {{promo.promoDescription}}. {{$productOrderCtrl.translations['antibody.pdp.commerceCard.promotion.learnmore']}}
产品信息
11117-1-AP
种属反应
已发表种属
宿主/亚型
分类
类型
抗原
偶联物
形式
浓度
规格
纯化类型
保存液
内含物
保存条件
运输条件
产品详细信息
Immunogen sequence: SYVALECAG FLAGIGLDVT VMVRSILLRG FDQDMANKIG EHMEEHGIKF IRQFVPIKVE QIEAGTPGRL RVVAQSTNSE EIIEGEYNTV MLAIGRDACT RKIGLETVGV KINEKTGKIP VTDEEQTNVP YIYAIGDILE DKVELTPVAI QAGRLLAQRL YAGSTVKCDY ENVPTTVFTP LEYGACGLSE EKAVEKFGEE NIEVYHSYFW PLEWTIPSRD NNKCYAKIIC NTKDNERVVG FHVLGPNAGE VTQGFAAALK CGLTKKQLDS TIGIHPVCAE VFTTLSVTKR SGASILQAGC UG (199-500 aa encoded by BC018122)
靶标信息
This gene encodes a member of the family of pyridine nucleotide oxidoreductases. This protein reduces thioredoxins as well as other substrates, and plays a role in selenium metabolism and protection against oxidative stress. The functional enzyme is thought to be a homodimer which uses FAD as a cofactor. Each subunit contains a selenocysteine (Sec) residue which is required for catalytic activity. The selenocysteine is encoded by the UGA codon that normally signals translation termination. The 3' UTR of selenocysteine-containing genes have a common stem-loop structure, the sec insertion sequence (SECIS), that is necessary for the recognition of UGA as a Sec codon rather than as a stop signal. Alternative splicing results in several transcript variants encoding the same or different isoforms.
仅用于科研。不用于诊断过程。未经明确授权不得转售。
生物信息学
蛋白别名: gene associated with retinoic and IFN-induced mortality 12 protein; Gene associated with retinoic and interferon-induced mortality 12 protein; GRIM-12; KM-102-derived reductase-like factor; MGC9145; NADPH-dependent thioredoxin reductase; oxidoreductase; Peroxidase TXNRD1; redox enzyme; selenoprotein oxidoreductase; selenoprotein TXNRD1; testis tissue sperm-binding protein Li 46a; Thioredoxin reductase 1, cytoplasmic; thioredoxin reductase GRIM-12; Thioredoxin reductase TR1; TR; TR alpha; TXNRD1; unnamed protein product
基因别名: GRIM-12; GRIM12; KDRF; TR; TR1; TRXR1; TXNR; TXNR1; TXNRD1
UniProt ID: (Human) Q16881, (Mouse) Q9JMH6
Entrez Gene ID: (Human) 7296, (Rat) 58819, (Mouse) 50493